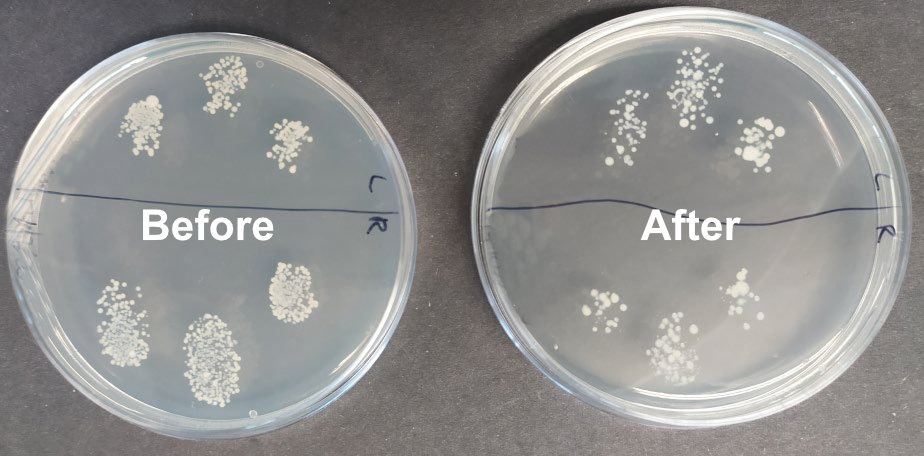

CSES@ARU Science and Engineering Saturday Club
Having just completed its second year, our Science and Engineering Saturday Club focuses on exploring the science and engineering behind real-life activities and problems that affect our health and wellbeing. As well as professionals and academics, the Club was supported by our medicine, science, engineering and business students, giving our members a unique opportunity to talk to current ARU students studying a range of STEM related courses they may be interested in. The programme enabled students to use state-of-the-art equipment in our unique Super Lab facilities and the workshop and computer laboratories at ARU's Chelmsford Campus. In addition to sessions on campus, the students visited external STEM related centres.
Overall, the students learnt a range of science and engineering skills including: Laboratory health and safety, microbiology, medical diagnostics, statistics, 3DCAD design and printing, pump engineering, clock construction and even bush craft!
Why do you need a holiday?
Looking at the upsides (reduce stress, see new places and experience new cultures) and the downsides (especially holiday infections and how they are transmitted).

The students developed microbiological skills cultivating their own skin bacteria. They looked at how effectively they could wash their hands but, despite all the advertising during the pandemic, many had just as many bacteria after washing with either alcohol gel or soap and water. Although the latter was the more effective!
They also took part in an "Agar Art" competition using bacteria as paint and incubating so that the bacteria grew and became visible with the top three winning Amazon vouchers as prizes.

Is sunshine really good for you?
Continuing the theme of holiday science we explored the positive effects of sunshine – vitamin D supporting bone health, lowering blood pressure, preventing disease, and promoting good mental health. And of course, some negative effects of too much sun – sunburn, skin cancer etc.
Using UV sensitive beads and UV lights, the students all successfully carried out experiments to determine which one of three potential sunscreen lotions was the most effective.
3D design and printing
Three sessions were held in the Faculty of Science and Engineering computer labs and workshop where the students were introduced to industry-standard computer aided design (CAD) software. After mastering the basics of CAD they each designed a wheeled vehicle from cars to boats and even a duck. The designs were exported to STL files, and the components 3D printed. During the final session, the students assembled their models and tested them on a ramp runway.

Epidemiology, vaccination and diagnosing Doris
We spent some sessions on how infections spread and the role of natural immunity following infections (herd immunity) and how this and vaccination is important in preventing and controlling epidemics and pandemics. The students explored antibodies in action by making unique antigens and corresponding antibodies with pipe cleaners.
In one session, they were given a case history of an elderly patient (Doris!) together with samples for bacterial analysis including the standard Gram stain technique. They were also given some "artificial urine" to simulate and determine a variety of biochemical urine sample parameters, including glucose, using clinical diagnostic dip sticks.

STEM careers
As technology develops, science and engineering skills are becoming increasingly important in almost every aspect of life, from health to car manufacturing, digital art and entertainment. The students took part in a STEM careers workshop organised for us by Make Happen, who run the Uni Connect programme for Essex. Students were able to explore the wide range of different science and engineering opportunities available. There was also an opportunity for parents or guardians to join to see where the students have been working and what future job opportunities might be available.
Water, water everywhere
Although there is a lot of water on our planet, less than 1% is available to drink. And while water shortages are often seen as a third-world problem, East Anglia has less water than some deserts! Together with global warming and our insatiable demand the UK needs 4 billion litres more water over the next 25 years!
Pumps are a vital piece of equipment to extract water and distribute it. The students learnt about the engineering aspects of valves and made their own hand water pump with two different types of valve from plastic syringes and other bits and pieces.
Keeping time
Time was the topic for this year's British Science Week. This session was organized and presented by a member of the Epping Horological society who brought along dozens of time pieces, a model of a 14th century clock, clocks and watches, a Meccano clock, huge clock springs, and tiny, tiny (1mm thick) fusee chains originally made by young girls in the workhouses!
During the session the students assembled their own electronic clocks.
External visits
Unfortunately, the visit to Broomfield Hospital was cancelled at the last minute because of NHS workloads. Our Leonardo visit was also sadly cancelled but was replaced by a morning at the Essex Wildlife Discovery Centre. The students explored the reservoir, did some bird watching and had an especially fun time learning how to light fires with a flint lighter. A competition to see how many times they could light a piece of cotton wool set a new Discovery Centre record of over 100 times! They also built bivouac shelters with ropes, long branches and tarpaulins. Some were good and some less so!

The NSC Master class was at the Blizzard Institute where the students learnt about "Air Pollution" and explored ways of measuring and reducing it.
Our final visit was to the newly refurbished Museum of Power in a former pumping station, where they saw an amazing variety of exhibits including the original massive triple expansion pumping engine in action.
